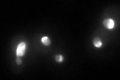
YHR052W
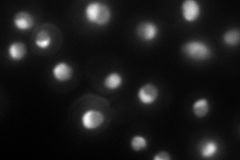
YHR052W

View description
Essential protein that interacts with proteasome components and has a potential role in proteasome substrate specificity; also copurifies with 66S pre-ribosomal particles
Localization:
Intensity:
Fold change:
Significance:
-
C’ GFP library in SD
nucleolus108.5 -
N' NOP1pr-GFP in SD
nucleolus116.021 -
N' TEF2pr-mCherry in SD

punctate,nucleus65.9684 -
N' NATIVEpr-GFP in SD

nucleus,nucleolus104.553 -
N' TEF2pr-VC and Cyto-VN in SD

nucleus,nucleolus51.9709 -
C’ GFP library in SD+DTT

nucleolus70.850.65Yes -
C’ GFP library in SD+H2O2

nucleolus105.540.97No -
C’ GFP library in Starvation Media

nucleolus78.140.72No -
C’ GFP library on the background of Pup2-DaMP

nucleolus -
C’ GFP library on the background of CCT mutant

nucleolus100.9940.930796No
